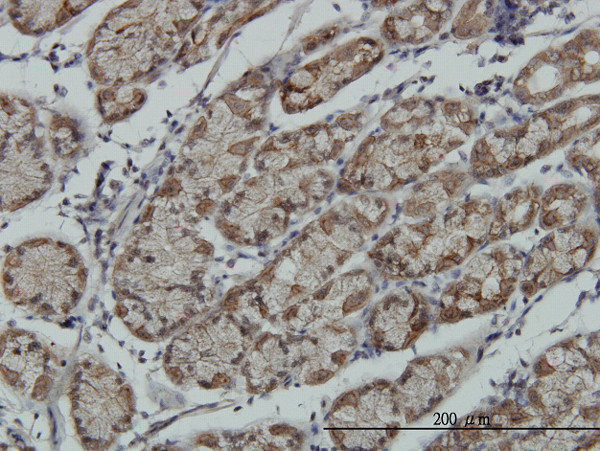
RPS6KA6 Antibody in Immunohistochemistry (Paraffin) (IHC (P))

Search
Abnova
RPS6KA6 Monoclonal Antibody (6F2)
{{$productOrderCtrl.translations['antibody.pdp.commerceCard.promotion.promotions']}}
{{$productOrderCtrl.translations['antibody.pdp.commerceCard.promotion.viewpromo']}}
{{$productOrderCtrl.translations['antibody.pdp.commerceCard.promotion.promocode']}}: {{promo.promoCode}} {{promo.promoTitle}} {{promo.promoDescription}}. {{$productOrderCtrl.translations['antibody.pdp.commerceCard.promotion.learnmore']}}
产品信息
H00027330-M02
种属反应
宿主/亚型
分类
类型
克隆号
抗原
偶联物
形式
浓度
规格
纯化类型
保存液
内含物
保存条件
运输条件
产品详细信息
Sequence of this protein is as follows: RIGNGKFSLS GGNWDNISDG AKDLLSHMLH MDPHQRYTAE QILKHSWITH RDQLPNDQPK RNDVSHVVKG AMVATYSALT HKTFQPVLEP VAASSLAQRR SMKKRTSTGL
靶标信息
RPS6KA6 (RSK4) is a member of the RSK kinases family. RSK family members are activated by ERKs and mitogens and are unusual in that they contain 2 non-identical kinase domains. RSK4 encodes a member of ribosomal S6 kinase family, serine-threonine protein kinases which are regulated by growth factors. The encoded protein may be distinct from other members of this family, however, as studies suggest it is not growth factor dependent and may not participate in the same signaling pathways.
仅用于科研。不用于诊断过程。未经明确授权不得转售。
篇参考文献 (0)
生物信息学
蛋白别名: 90 kDa ribosomal protein S6 kinase 6; p90-RSK 6; pp90RSK4; Ribosomal protein S6 kinase alpha-6; ribosomal protein S6 kinase, 90kDa, polypeptide 6; Ribosomal S6 kinase 4; RPS6KA6; RSK-4; S6K-alpha 6; S6K-alpha-6; S6KA6; unnamed protein product
基因别名: p90RSK6; PP90RSK4; RGD1560817; RPS6KA6; RSK-4; RSK4; S6K-alpha-6
UniProt ID: (Human) Q9UK32
Entrez Gene ID: (Human) 27330, (Rat) 317203